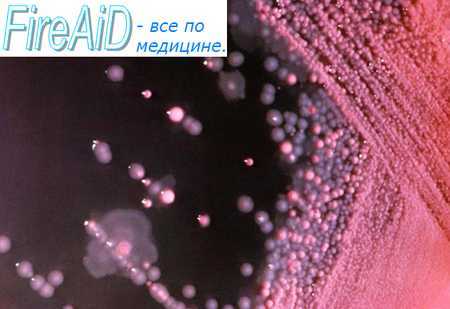
Круговорот серы. Сульфатное дыхание бактерий. Диссимиляционная сульфатредукция

Круговорот серы. Сульфатное дыхание бактерий. Диссимиляционная сульфатредукция.
Добавил пользователь Алексей Ф. Обновлено: 11.12.2025
Сульфатное дыхание - это процесс окисления в анаэробных условиях субстрата (органических соединений или молекулярного водорода), при котором в качестве конечного акцептора электронов выступает сульфат, в результате чего происходит его восстановление до H2S. Бактерии, осуществляющие этот процесс, получили название сульфатвосстанавливающих или сульфатредуцирующих.
Биологические свойства сульфатвосстанавливающих бактерий:
1) Строгие анаэробы.
2) Разнообразны по морфологическим, физиологическим и биохимическим признакам.
3) В настоящее время в состав группы сульфатвосстанавливающих бактерий входит более 40 видов.
4) Практически все сульфатвосстанавливающие бактерии имеют клеточную стенку грамотрицательного типа.
5) Среди них есть и одноклеточные, и нитчатые формы.
6) Сульфатвосстанавливающие бактерии могут получать энергию для роста разными способами. Некоторые виды растут на средах с органическими субстратами без сульфатов. В этом случае единственным источником энергии служит процесс брожения, при котором АТФ синтезируется в реакциях субстратного фосфорилирования. Основными субстратами являются пируват, лактат, этанол, при сбраживании которых выделяется молекулярный водород. Однако специфическим способом получения энергии, послужившим основанием для выделения ряда прокариот в отдельную физиологическую группу – группу сульфатвосстанавливающих бактерий, является сульфатное дыхание.
Получение энергии в результате сульфатного дыхания состоит из трех этапов:
отрыва электронов от энергетического субстрата;
переноса электронов по дыхательной цепи;
присоединения электронов к веществам, функционирующим в качестве конечных акцепторов электронов.
(1) Этап отрыва электронов от энергетических субстратов катализируют различные субстратные ферменты (лактат-, пируват-, этанолдегидрогеназы) и гидрогеназы. С их помощью электроны передаются сразу в дыхательную цепь.
(2) В качестве компонентов дыхательной цепи у сульфатвосстанавливающих бактерий идентифицированы флавопротеины, FeS-белки (ферредоксин, рубредоксин), хиноны (типа менахинона), цитохромы b и с. Особенностью дыхательной цепи многих сульфатвосстанавливающих бактерий является высокое содержание цитохрома с3. Точная локализация компонентов, их последовательность в дыхательной цепи пока достоверно не установлены. Однако установлено, что окисление, в частности Н2, происходит на наружной стороне мембраны, а реакции восстановления SO4 2- – на внутренней. Перенос электронов по дыхательной цепи сопровождается возникновением электрохимического градиента с последующим генерированием энергии в молекулах АТФ.
(3) Последний этап, который заключается в акцептировании сульфатом электронов с помощью нескольких редуктаз, называется собственно диссимиляционной сульфатредукцией.
У некоторых микроорганизмов, использующих в качестве источника серы сульфаты, происходит ассимиляционная сульфатредукция. При этом происходит восстановление сульфата до сульфида, который затем идет на синтез серосодержащих аминокислот. Основные отличия диссимиляционной сульфатредукции от ассимиляционной сводятся к следующему:
• диссимиляционное восстановление сульфата присуще только узкому кругу высокоспециализированных прокариотических организмов;
- активность процессов диссимиляционной сульфатредукции намного выще, чем ассимиляционных, следствием чего является накопление в среде больших количеств Н2S,
- механизмы обоих процессов различны.
Распространение и значение сульфатвосстанавливающих бактерий. Сульфатвосстанавливающие бактерии распространены в анаэробных зонах водоемов разного типа, почвах и пищеварительном тракте животных. Наиболее интенсивно восстановление сульфатов происходит в соленых озерах и морских лиманах, где почти нет циркуляции воды и содержится много сульфатов, вызывая замор рыбы.
Сульфатвосстанавливающие бактерии участвуют в биологическом круговороте серы в природе. Являясь основными продуцентами сероводорода, они могут приносить вред, вызывая коррозию металлических труб и других подводных и подземных сооружений:
4Fе 2+ + Н2S + 2ОН - + 4Н2О → FеS + 3Fе(ОН)2 + 6Н +
Круговорот серы. Сульфатное дыхание бактерий. Диссимиляционная сульфатредукция.
I. Экология микроорганизмов - статьи для получения базовых знаний
II. Экология микроорганизмов - статьи для получения углубленных знаний
1. Условно-патогенные микроорганизмы (возбудители оппортунистических инфекций)
- Род Staphylococcus
- Род Streptococcus
- Род Enterococcus
- Коринебактерии (Corynebacteria)
- Нетуберкулезные микобактерии (Mycobacterium)
- Условно-патогенные нейссерии (Neisseriae)
- Моракселлы (Moraxella (Branhamella) catarrhalis)
- Энтеробактерии (Enterobacteriaceae)
- Псевдомонады (Pseudomonas)
- Буркхольдерии (Burkholderia)
- Stenotrophomonas maltophilia
- Ацинетобактеры (Acinetobacter)
- Возбудители анаэробной (неклостридиальной) инфекции
- Clostridium difficile
- Грибы как возбудители оппортунистических инфекций
- Дрожжевые грибы рода Candida
- Возбудитель пневмоцистоза (Pneumocystis carinii (jiroveci hominis))
- Другие дрожжевые грибы
- Темноокрашенные гифомицеты
- Гиалиновые гифомицеты
- Зигомицеты
- Грибы - возбудители редких микозов
- Лабораторная диагностика оппортунистических микозов
- Возбудители криптоспоридиоза
2. Нормальная микрофлора человека
3. Внутрибольничные инфекции
- Нарушения иммунитета
- Сепсис
- Синдром полиорганной недостаточности (СПОН)
- Оппортунистические инфекции мягких тканей
- Оппортунистические инфекции в травматолого-ортопедических клиниках
- Оппортунистические инфекции при ожоговой травме
- Воспалительные заболевания полости рта и челюстно-лицевой области
- Внутрибольничный сальмонеллез (ВБС)
- Ассоциированные с инфекцией болезни кишечника
- Оппортунистические инфекции в кардиологии
- Оппортунистические инфекции в ревматологии
- Оппортунистические инфекции в урологии
- Микобактериозы
- Оппортунистические инфекции в дерматологии
- Оппортунистические инфекции у онкологических больных
- Оппортунистические инфекции у онкогематологических больных
- Оппортунистические инфекции при ВИЧ и СПИД
- Оппортунистические инфекции у пожилых
4. Эпидемиология внутрибольничных оппортунистических инфекций
- Эпиднадзор в роддомах и отделениях гинекологии
- Эпиднадзор в отделениях реанимации новорожденных детей
- Эпиднадзор в детских инфекционных стационарах
- Эпиднадзор в отделениях реанимации (ОРИТ)
- Эпиднадзор в хирургических отделениях
- Эпиднадзор в ожоговых отделениях
- Эпиднадзор в ЛОР-отделениях
- Эпиднадзор в офтальмологических отделениях
- Эпиднадзор в психиатрических стационарах
- Эпиднадзор в отделениях неврологии
- Болезнь Крейтцфельдта-Якоба (БКЯ)
- Эпиднадзор в эндоскопии
- Эпиднадзор за нетуберкулезными микобактериями (НТМБ)
- Эпиднадзор за туберкулезом
- Эпиднадзор за пневмоцистозом
5. Профилактика и лечение ВБИ
- Иммунотерапия ВБИ
- Дисбактериоз
II. Экология микроорганизмов - статьи на основе архивных материалов давности более 20 лет
Информация на сайте подлежит консультации лечащим врачом и не заменяет очной консультации с ним.
См. подробнее в пользовательском соглашении.
Во всех организмах сера представлена главным образом сульфгидрильными (-SH) или дисульфидными (-S-S-) группами метионина, цистеина и гомоцистеина. При анаэробном разложении белков сульф гидр ильные группы отщепляются десульфуразами, при этом выделяется сероводород. Этот процесс напоминает аммонификацию азотсодержащих органических соединений. Наибольшее количество сероводорода образуется при диссимиляционном восстановлении сульфатов (диссимиляционная сульфатредукция, или «сульфатное дыхание»), осуществляемом облигатно анаэробными бактериями (бактерии родов Desulfovibrio, Desutfotomaculum, Desulfococcus, Desulfosarcina, Desulfonema).
Последние используют сульфат для окисления низкомолекулярных органических соединений или молекулярного водорода. Диссимиляционное восстановление элементной серы в анаэробных условиях способны осуществлять бактерии рода Desulfuromonas. Сульфатредуцирующие (или десульфатирующие) бактерии в круговороте серы играют роль, сопоставимую с ролью нитратредуцирующих бактерий в круговороте азота. Их деятельность заметна на дне прудов, вдоль побережья моря по чёрному цвету ила (связан с образованием сульфида двухвалентного железа) и запаху (за счет выделения сероводорода). Из-за токсического действия сероводорода некоторые береговые области иногда практически безжизненны.
• Образованный в отсутствие молекулярного кислорода сероводород может быть окислен анаэробными фототрофными бактериями семейства Chromatiaceae до серы (виды Chlorobium) или до сульфата (виды Chromatium). В этом семействе известны бактерии, накапливающие серу внутри клеток в качестве промежуточного продукта окисления сероводорода (виды Thiospirillum, Chromatium, Thiodiction), и бактерии, откладывающие серу вне клеток (виды Ectothiorhodospira).
• В аэробных условиях сероводород под действием бесцветных серобактерий (виды Beggiatoa, Thtothrix) окисляется (через промежуточное образование серы) в сульфат. Сероводород может также окисляться в присутствии кислорода абиотическим путём. Свободную серу в аэробных условиях могут окислить до сульфата представители рода Thiobacillus. Некоторые из них — хемолитотрофы, другие используют в качестве источников энергии и углерода органические соединения.
• Образуя большие количества серной кислоты, тиобациллы уменьшают щелочность почвы, переводя карбонат кальция в лучше растворимый сульфат кальция, вымываемый из почвы. Таким образом, добавляя в известковые почвы элементную серу, можно бороться с их избыточным известкованием. Что касается серы, необходимой для синтеза серосодержащих аминокислот, то она поступает в организм животных с пищей, содержащей восстановленные соединения серы; растения и часть микроорганизмов получают её в процессе ассимиляционной сульфатредукции. Как и при ассимиляции нитрата, ассимилируется ровно столько питательных веществ, содержащих серу или азот, сколько их необходимо для роста организма; поэтому никакие восстановленные продукты метаболизма серы в окружающую среду не выделяются.
Сульфатное дыхание
При сульфатном дыхании конечным акцептором электронов служит сульфат. Физиологическую группу микроорганизмов, восстанавливающих сульфат, называют сульфатредукторами, или сульфидогеиами. Эта группа объединяет представителей с разным систематическим положением, причем названия их родов часто начинаются с приставки Desulfo- (табл. 7.2). В отличие от нитратредукторов, все сульфатредукторы — облигатные анаэробы.
Некоторые сульфатредукторы различных таксономических групп
Домен Bacteria
Desulfotomaculum
Desulfosporosinus
Грамположительные, разные по морфологии микроорганизмы, образующие эндоспоры. Есть представители, способные как к полному, так и к неполному окислению субстратов. Некоторые — автотрофы, азотфиксаторы, термофилы. Имеют цит b (с), не содержат десульфовиридина
Desulfobacterium
Мелкие палочки с полным окислением субстратов, некоторые — автотрофы
Desulfococcus
Кокки, полностью окисляющие субстраты
Desulfonema
Нити, передвигающиеся скольжением. Полностью окисляют ацетат
Thermodesulfobacterium
Термофильные палочки с неполным окислением субстратов
Desulfosarcina
Крупные кокки в кубовидных пакетах с полным окислением ацетата
Desulfovibrio
Подвижные вибрионы, содержащие цит с, b и десульфови- ридин. Имеют незамкнутый ЦТК
Домен Archaea
Archaeoglobus fulgidus
Архей с нерегулярной формой клеток из морского гидротермального источника. Кроме сульфата, хорошо восстанавливает тиосульфат с глюкозой, формиатом, формами- дом, лактатом, пируватом в качестве доноров электронов. 112 может быть донором при росте с тиосульфатом, но не с сульфатом. Элементарную серу не восстанавливает
Сульфатное дыхание является диссимиляционной сульфатредукцией.
Сульфат восстанавливается в соответствии со следующей реакцией:
Первая стадия диссимиляционного и ассимиляционного процессов одинакова, а все последующие проводятся разными ферментами (рис. 7.16).

Рис. 7.16. Последовательность реакций при диссимиляционной и ассимиляционной сульфатредукции
Донорами электронов при сульфатном дыхании могут служить молекулярный водород, органические кислоты, спирты и другие органические соединения. Сульфатредукгоры способны расти гетеротрофно, причем часть их окисляет органические вещества до воды и углекислого газа, а другие осуществляют неполное окисление с образованием ацетата из-за отсутствия а-кетоглутаратдегидрогеназы в ЦТК. При истощении сульфата и наличии органических веществ сульфатредукторы могут переходить на сбраживание молочной и пировиноградной кислот с образованием ацетата и Н2. В таких условиях они становятся синтрофами, для которых обязательно присутствие группы микроорганизмов, потребляющих молекулярный водород. У автотрофных сульфатредукторов (Н2/С02 и SO 2- ) присутствует ацетил-КоА-путь фиксации С02 (путь Вуда — Лыонгдала), такой же как у гомоацетогенов, с ключевым ферментом СО-дегидрогеназой- ацетил-КоА-синтазой.
Сульфатвоссганавливающие микроорганизмы обычно обитают в морских донных осадках и являются важным звеном глобального круговорота серы. Большая часть сероводорода в природе возникает именно благодаря сульфатному дыханию. Образующийся сульфид служит донором электронов при бактериальном фотосинтезе. В то же время накопление сероводорода в водоемах может вызывать замор рыб. Деятельность сульфатредукторов приводит к коррозии металла (рис. 7.17) и бетона. При тесном контакте клеток с поверхностью железа возникает катодная поляризация, при которой Fe° донирует электроны сульфату внутри клеток при посредничестве периплазматического гидрогеназного ферментного комплекса. Образованный ион Fe 2+ либо используется клетками для целей анаболизма, либо связывается экстрацеллюлярно с сульфидом, полученным в результате сульфатного дыхания. При этом структура металла разрушается.

Рис. 7.17. Процесс разрушения железа сульфатредукторами
На нефтяных месторождениях биокоррозия труб нефтепроводов в немалой степени связана с развитием на их внутренних поверхностях биопленок, содержащих клетки сульфатредукторов.
Помимо сульфатного дыхания, восстановление сульфата может осуществляться бактериями, грибами и растениями в процессе ассимиляционной сульфатредукции. В этом случае сера в виде сульфида затем включается в серосодержащие аминокислоты и белки.
49. Питание микроорганизмов. Источники серы. Восстановление и окисление серы и серосодержащих веществ. Сульфатредукция.
В природе сера находится в виде неорганических солей, главным образом сульфатов, в виде молекулярной элементарной серы и в составе органических веществ (аминокислот, витаминов, кофакторов). Процессы, в которых бактерии включают серу и ее соединения в свой метаболизм можно разделить на окисление элементарной серы и ее восстановленных соединений и сульфатредукцию.
Способностью получать энергию в результате окисления восстановленных соединений серы обладают грамотрицательные бактерии с полярно расположенными жгутиками, объединяемые в роды Thiobacillus и Thiomicrospira, а также неподвижные термофильные бактерии рода Sulfolobus.
Большинство тиобацилл может окислять различные соединения серы, образуя в качестве конечного продукта сульфат:
S + Н2О + 1,5O2 = SО42- + 2Н +
S2O32- + Н2О + 2О2 = 2SО42- + 2Н +
Многие тиобациллы облигатные хемолитоавтотрофы, фиксирующие СО2.
Другие (Т. novellas, Т. intermedius) способны также использовать в качестве источников энергии и углерода органические соединения. Т. thiooxidans образует большие количества серной кислоты и хорошо переносит низкие значения рН среды.
В результате декарбоксилирования серосодержащих аминокислот образуются меркаптаны, метиламин, серводород, метан.
* Диссимиляционная сульфатредукция – анаэробный процесс восстановления сульфатов до сероводорода («сульфатное дыхание»). Главным продуктом реакции является сероводород:
8[H] + SO4 2- = H2S + 2H2O + 2OH-
К сульфатредукторам относят бактерии 7 группы по классификатору Берджи родов, имеющих приставку Desulfo-.
роды Desulfotomaculum и Desulfobacter представлены палочковидными бактериями
род Desulfovibrio – изогнутыми бактериями
род Desulfogigas – спириллами
роды Desulfococcus и Desulfosarcina – кокками
род Desulfonema – нитчатыми формами.
По степени усвоения органических кислот различают две группы сульфатредуцирующих бактерий:
Бактерии, относящиеся к первой группе, окисляют донор водорода не полностью и выделяют уксусную кислоту. Таковы виды спорообразующего рода Desulfotоmaculum и неспорообразующего рода Desulfovibrio.
Вторая группа включает роды и виды, часть которых может расти, используя спирты, ацетат, высшие жирные кислоты или бензоат, а другие способны даже к хемоавтотрофному росту в присутствии водорода и формиата. К этой группе относятся спорообразователи (Desulfotomaculum acetoxidans), а также неспорообразующие палочки (Desulfobacter), кокки (Desulfococcus), сарцины (Desulfosarcinа), нитевидные формы, передвигающиеся путем скольжения (Desulfonema),и некоторые другие бактерии.
*Ассимиляционная сульфатредуция. Почти все бактерии, грибы и зеленые растения способны использовать в качестве источника серы сульфат. Они получают сульфид, необходимый для синтеза серосодержащих аминокислот, путем ассимиляционной сульфатредукции.
Первая реакция на этом пути является общей как для диссимиляционного, так и для ассимиляционного восстановления сульфата.
Далее при диссимиляционной сульфатредукции происходит прямое восстановление активированного сульфата, а при ассимиляционной следует еще одна реакция активации, на которую непосредственно затрачивается энергия АТФ; с помощью АТФ-сульфурилазы (сульфатаденилтрансферазы) дифосфатный остаток АТФ обменивается на сульфат:
АТФ + SO42- = Аденозин-5`-фосфосульфат + PPi
Дифосфат (пирофосфат) расщепляется пирофосфатазой.
Продуктом активации является аденозин-5-фосфосульфат.
На пути ассимиляционного восстановления сульфата АФС с помощью АФС-киназы и АТФ фосфорилируется у ряда организмов с образованием фосфоаденозинфосфосульфата (ФАФС); лишь этот вдвойне активированный сульфат восстанавливается сначала до сульфита, а затем до сульфида.
Читайте также:
- Гипохромные анемии - причины, классификация
- Операция Якобеуса при двусторонних процессах. Операция Якобеуса при двусторонних пневмотораксах
- Лечение ботулизма. Противоботулиническая антитоксическая сыворотка. Антисыворотка при ботулизме. Профилактика ботулизма. Предупреждение ботулизма.
- Клиника гнойного менингита. Неврологические симптомы гнойного менингита. Тактика при гнойном менингите.
- Респираторно-синцитиальный вирус и инфекция, вызванная человеческим метапневмовирусом
